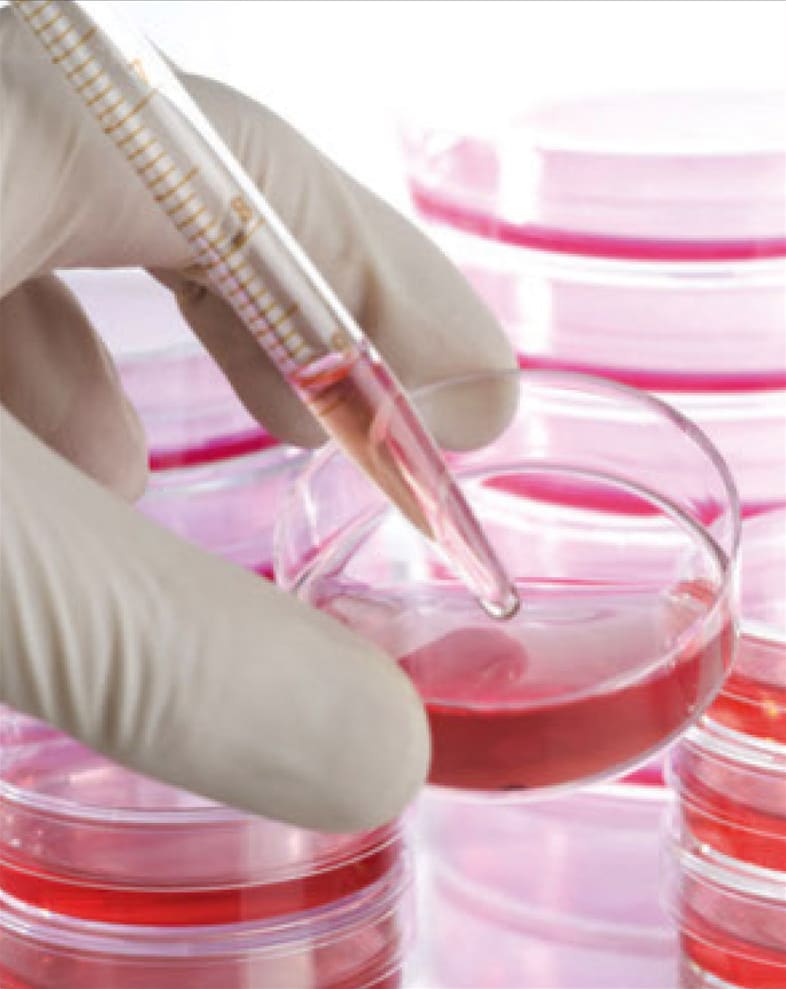

This column presents technologies that have applications in commercial areas, possibly creating the products of tomorrow. To learn more about each technology, see the contact information provided for that innovation.
Gel-Like Fluid Prevents Wildfires

Stanford University developed a long-lasting, environmentally benign, fire-retarding treatment that, if used on high-risk areas, could dramatically cut the number of fires that occur each year. The gel-like fluid helps common wildland fire retardants last longer on vegetation. Applied to ignition-prone areas, the materials retain their ability to prevent fires throughout the peak fire season, even after weathering that would sweep away conventional fire retardants. By stopping fires from starting, such treatments can be more effective and less expensive than current firefighting methods. The treatment contains only nontoxic starting materials widely used in food, drug, cosmetic, and agricultural products. While it washes away slowly, the materials eventually degrade.
Contact: Eric Appel, School of Engineering
Phone: 562-320-877
E-mail: This email address is being protected from spambots. You need JavaScript enabled to view it.
High-Quality Tissue Formation Method
NASA Johnson Space Center has developed the High-Density Spot Seeding (HDSS) method to create 2D and 3D tissue models for applications including wound treatment, therapy, and tissue modeling of skeletal muscle, cardiac muscle, nerve, and bone. The technique uses a four-step method that does not require expensive reagents and has the potential to yield superior-quality tissue samples. The technology enables the creation of unique models for R&D and even regenerative medicine. It can also be used as an in-vitro tissue model for drug screening and toxicology testing in the pharmaceutical development field.
Contact: Johnson Space Center
Phone: 281-483-3809
E-mail: This email address is being protected from spambots. You need JavaScript enabled to view it.
https://technology.nasa.gov/patent/MSC-TOPS-41
Photovoltaic Solar Cell Works at Night

A photovoltaic cell, developed at the University of California, Davis, could generate up to 50 watts of power per square meter under ideal conditions at night — about a quarter of what a conventional solar panel can generate in the daytime. A regular solar cell generates power by absorbing sunlight, which causes a voltage to appear across the device and for current to flow. In the new device, light is instead emitted and the current and voltage go in the opposite direction but power is still generated. The device would work during the day as well if steps were taken to either block direct sunlight or point it away from the Sun.

